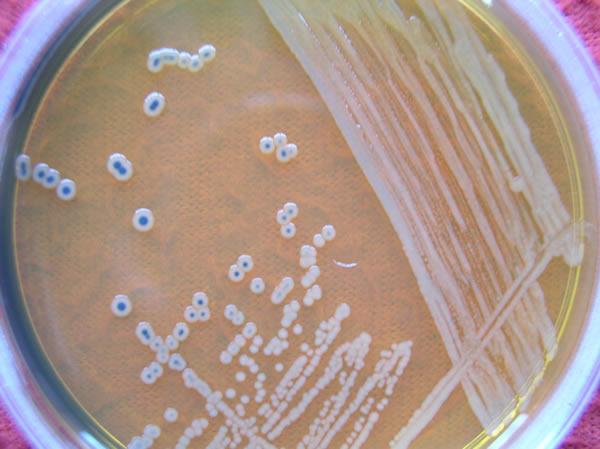

菌株编号:
中文名:
英文名:
别称:
类别:
E值:
覆盖率:
气他环境:
品牌:
肉品种类:
来源地址:
最大量:
总量:
| 精确查询> |